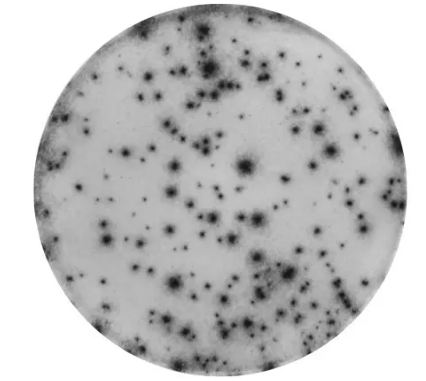
Mabtech

PRODUCT CENTER
特色產(chǎn)品當(dāng)前位置:首頁 > 特色產(chǎn)品
酶聯(lián)免疫斑點(ELIspot )的結(jié)果好壞與多種因素有關(guān),刺激物的種類與質(zhì)量就是多種因素之一,一方面,即使細胞狀態(tài)再好,如果刺激物不能形成有效的刺激,那也不會出現(xiàn)ELIspot斑點;另一方面,如果刺激物不純,那么即使刺激出了斑點,也不見得是想要的斑點。
常用的陽性刺激物包括非特異性刺激物(PHA,LPS,Con-A等)和特異性刺激物(T細胞表位肽、重疊多肽庫等),其中T細胞表位肽是最好的特異性刺激物,無需APC的內(nèi)化和加工,可直接被遞呈給T細胞,每一條T細胞表位肽都有相對應(yīng)的MHC分子,代表了一種特異性的細胞免疫,多條T細胞表位肽混合起來形成T細胞表位肽庫或肽池,國際上通用的標(biāo)準(zhǔn)陽性刺激物CEF就是這樣一個T細胞表位肽池,有32條多肽混合而成,分別取自于人類巨細胞病毒(CMV)、人類皰疹病毒(EBV)和流感病毒。MabTech有多種的T細胞表位肽,包括CEF肽池、CEF擴展肽池、CEFTA肽池、CMV肽池和EBV肽池等。
艾美捷Mabtech 蛋白池:CEF(CD8),人類:
貨號 3616-1
應(yīng)用 T細胞刺激,ELISpot,F(xiàn)luoroSpot,流式細胞術(shù)
反應(yīng)性 人類
提供形式 凍干粉
內(nèi)容 包含23個肽的肽池,每個肽25微克。在一個瓶中提供(凍干粉)。
運輸 常溫運輸。
儲存 收到后儲存在-20°C或更低溫度下。
用CEF肽池刺激的人PBMC在人IFN-γELISpot中的表達。使用Mabtech IRIS進行分析。
蛋白池:CEF(CD8),人類旨在作為免疫測定中的陽性對照,如ELISpot、FluoroSpot和流式細胞術(shù)。它能誘導(dǎo)抗原特異性的人類CD8 T細胞分泌細胞因子。僅限研究使用,不得用于診斷程序。
CEF肽池能誘導(dǎo)人類CD8 T細胞分泌例如IFN-γ、IL-2和顆粒酶B等細胞因子。它包含來自人類巨細胞病毒(CMV)、EB病毒和流感病毒的23個MHC I類限制性病毒肽。已被證明能在幾乎所有90%的高加索人中誘導(dǎo)IFN-γ反應(yīng)。合成肽的純度超過95%。
CEF肽池覆蓋的已發(fā)表的HLA類型:
HLA-A1、HLA-A2、HLA-A3、HLA-A11、HLA-A24、HLA-A68、HLA-B7、HLA-B8、HLA-B27、HLA-B35、HLA-B44
CEF肽池中包含的肽列在數(shù)據(jù)表中。
艾美捷科技是Mabtech的中國代理商,為科研工作者提供優(yōu)質(zhì)的產(chǎn)品與服務(wù)。
微信掃碼在線客服